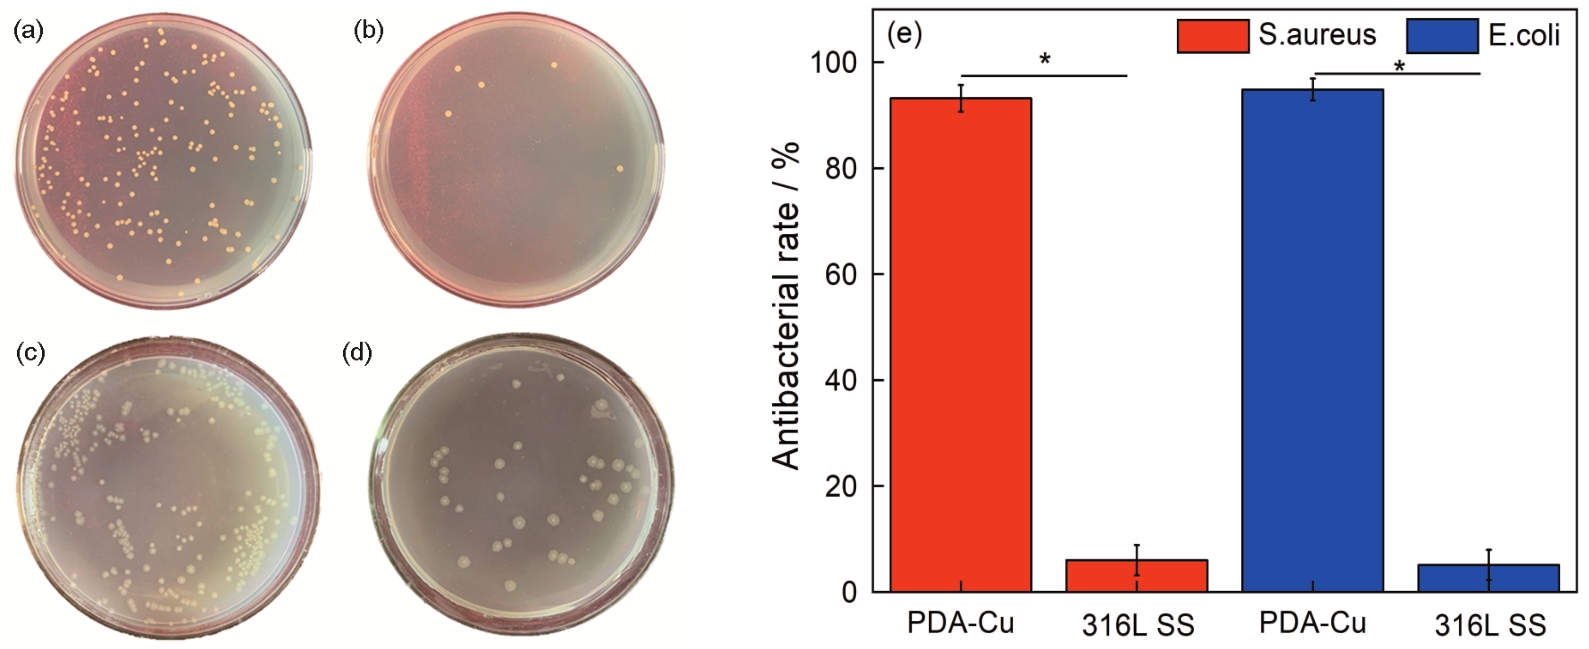

输尿管支架表面化学接枝镀铜涂层及其性能
Preparation and Properties of Copper-carrying Polydopamine Coating on Ureteral Stent

输尿管支架表面化学接枝镀铜涂层及其性能 |
| 李建中, 朱博轩, 王振宇, 赵静, 范连慧, 杨柯 |
|
Preparation and Properties of Copper-carrying Polydopamine Coating on Ureteral Stent |
| LI Jianzhong, ZHU Boxuan, WANG Zhenyu, ZHAO Jing, FAN Lianhui, YANG Ke |
| 图8 材料与细菌浸泡培养30 d后活细菌的数量和抗菌率 |
| Fig.8 Live bacteria number and antibacterial rate of different samples after immersion for 30 d (a) S.aureus, 316L SS; (b) S.aureus, copper loaded polydopamine coating; (c) E.coli, 316L SS; (d) E.coli, copper loaded polydopamine coating; (e) antibacterial rate |
|